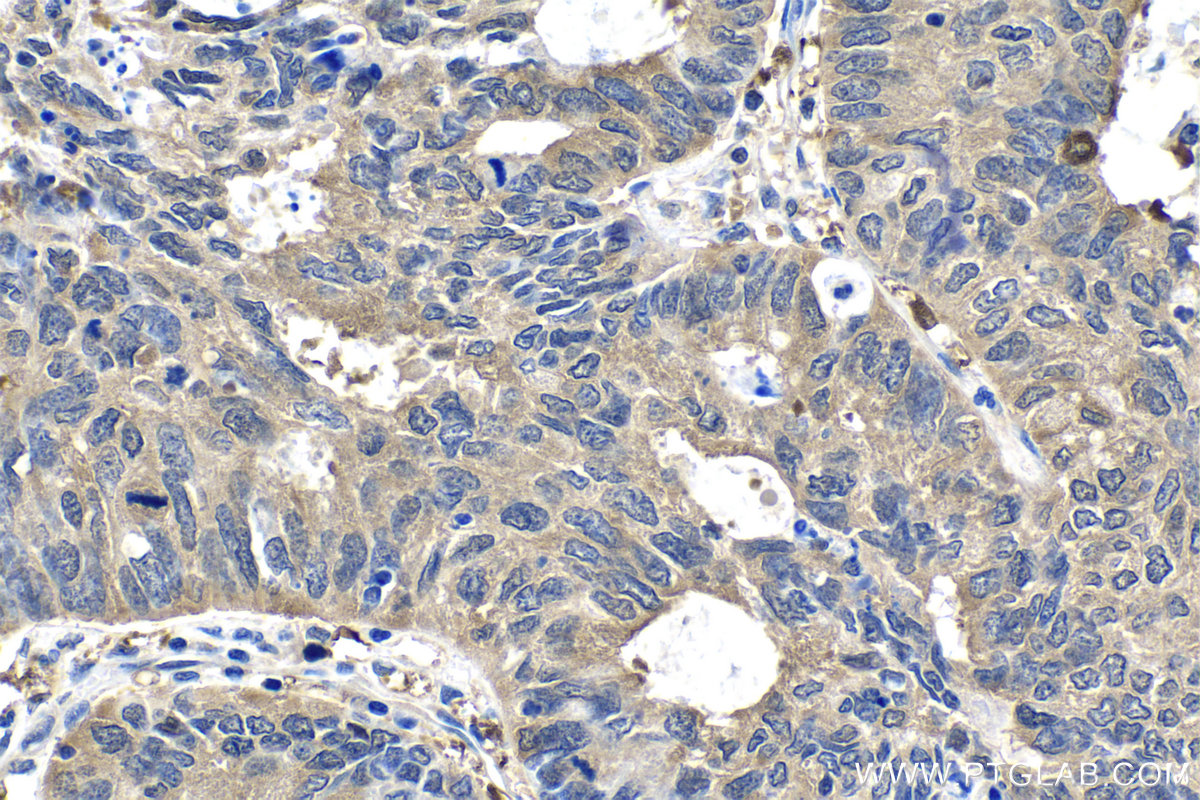

IHCeasy® RAF1 Ready-To-Use IHC Kit
RAF1 Ready-to-use reagent kit for IHC.
Reactivity
Human, Mouse, Rat
Sample Type
FFPE tissue
Cat no : KHC1506
Synonyms
c Raf, CRAF, NS5, Proto oncogene c RAF, RAF, Raf 1, RAF1
Validation Data Gallery
Product Information
KHC1506 is a ready-to-use IHC kit for staining of RAF1. The kit provides all reagents, from antigen retrieval to cover slip mounting, that require little to no diluting or handling prior to use. Simply apply the reagents to your sample slide according to the protocol and you're steps away from obtaining high-quality IHC data.
| Product name | IHCeasy RAF1 Ready-To-Use IHC Kit |
| Sample type | FFPE tissue |
| Assay type | Immunohistochemistry |
| Primary antibody type | Rabbit Polyclonal |
| Secondary antibody type | Polymer-HRP-Goat anti-Rabbit |
| Reactivity | Human, Mouse, Rat |
Kit components
| Component | Size | Concentration |
|---|---|---|
| Antigen Retrieval Buffer | 100 mL | 50× |
| Washing Buffer | 100 mL ×2 | 20× |
| Blocking Buffer | 5 mL | RTU |
| Primary Antibody | 5 mL | RTU |
| Secondary Antibody | 5 mL | RTU |
| Chromogen Component A | 0.2 mL | RTU |
| Chromogen Component B | 4 mL | RTU |
| Signal Enhancer | 5 mL | RTU |
| Counter Staining Reagent | 5 mL | RTU |
| Mounting Media | 5 mL | RTU |
| Datasheet | 1 Copy | |
| Manual | 1 Copy |
Background Information
Raf-1 proto-oncogene, serine/threonine kinase(RAF1), is a MAP kinase kinase kinase (MAP3K), which functions downstream of the Ras family of membrane associated GTPases to which it binds directly. RAF1 plays an important role in the control of gene expression involved in the cell division cycle, apoptosis, cell differentiation and cell migration.
Properties
| Storage Instructions | All the reagents are stored at 2-8°C. The kit is stable for 6 months from the date of receipt. |
| Synonyms | c Raf, CRAF, NS5, Proto oncogene c RAF, RAF, Raf 1, RAF1 |